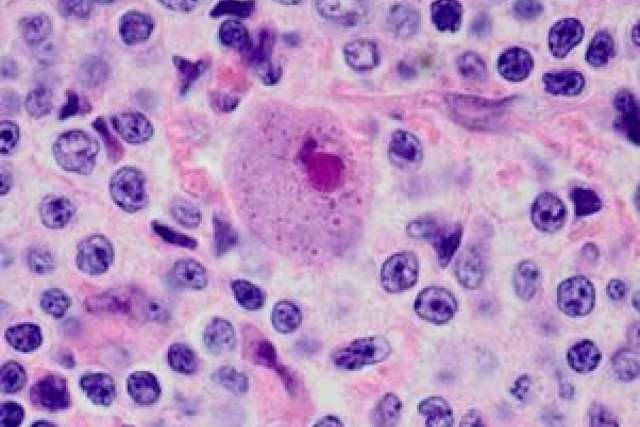

UCLA, UC San Francisco and City of Hope have received a five-year, $8 million grant from the National Institute of Allergy and Infectious Diseases to study how a common virus called cytomegalovirus may provoke the immune system to reject transplanted kidneys.
The 14-member interdisciplinary team is co-led by Elaine Reed, who holds the Daljit S. and Elaine Sarkaria Endowed Chair in Diagnostic Medicine at UCLA and is director of the UCLA Immunogenetics Center.
“Nearly 70 percent of people around the world carry antibodies to the cytomegalovirus infection, yet healthy people rarely display symptoms,” said Reed, who also is a professor of pathology at the David Geffen School of Medicine at UCLA. “In a transplant patient, however, CMV is one of the leading causes of organ failure and death.”
In 2016, U.S. medical centers performed 33,611 transplants, including 19,062 for kidneys, according to the Department of Health and Human Services. An estimated 15 percent of kidney transplant patients develop CMV infections following surgery.
“We intend to translate our discoveries into improved care and life-saving treatments for transplant patients who are predisposed to CMV infection,” Reed said.
To identify new strategies for treating kidney transplant patients with CMV, the consortium will study two types of immune responses.
The first type, innate immune response, is a general inflammatory reaction that provides the first line of defense against infections by clearing disease-causing agents from the immune system. Innate responses also trigger a second type of response — adaptive immune responses, which are delayed reactions to a specific stimulus. Adaptive immunity is important because it delivers long-lasting protection against a particular virus or bacteria.
“Our goal is to create a molecular map of the cross-talk between the patient’s innate and adaptive immune responses,” Reed said. “We suspect that the transplant patient’s compromised immune response to CMV infection influences organ rejection and long-term outcomes.”
The researchers hope to uncover useful clues for developing more effective vaccines against CMV. They also will profile the immune systems of transplant recipients who are able to fight off CMV and those of people who suffer persistent infection, which will enable them to better identify high-risk patients.
“The UCLA–UCSF–City of Hope consortium draws on an exciting breadth of expertise,” said Stephen Smale, vice dean for research at the Geffen School of Medicine. “The team includes outstanding scientists whose specialties extend from transplant immunology and infectious disease to genomics and computational immunology.”
The medical school’s Immunity, Inflammation, Infection and Transplantation research theme, or I3T, played a critical role in positioning UCLA to take a lead role in the research, according to Smale. I3T has encouraged significant cooperation between researchers from several academic disciplines at UCLA.
“The I3T theme essentially served as our think tank,” Reed said. “It brought together our UCLA experts in immunology, transplantation, genomics, biostatistics and computational immunology community to build an investigative team equipped to successfully compete for this award and accomplish the research objectives.”
The grant’s co-principal investigator is Minnie Sarwal, a professor at UC San Francisco. The team’s other members are Suphamai Bunnapradist, Mario Deng, David Elashoff, David Gjertson, Alexander Hoffman, Maura Rossetti, Joanna Schaenman and Otto Yang of UCLA; Lewis Lanier, Marina Sirota and Flavio Vincenti of UCSF; and Don Diamond of City of Hope.
Learn more about UCLA’s Immunity, Inflammation, Infection and Transplantation research theme, or I3T.